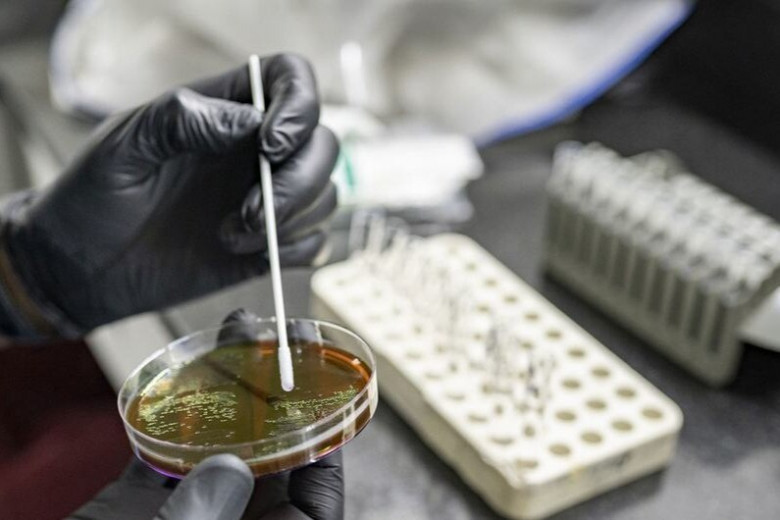

ԱՄՆ-ում արձանագրվել է թռչնագրիպի H5N5 շտամով վարակման առաջին դեպքը
ՄԻՋԱԶԳԱՅԻՆ
Ամերիկայի Միացյալ Նահանգներում արձանագրվել է թռչնի գրիպի H5N5 շտամով վարակման առաջին դեպքը։ «Արմենպրես»-ի փոխանցմամբ՝ այս մասին հայտնել է Վաշինգտոն նահանգի Առողջապահության դեպարտամենտը։
«Թռչնագրիպի ենթատեսակով վարակված քաղաքացին ախտանշաններով հոսպիտալացվել էր նոյեմբերի սկզբին, նրա մոտ արձանագրվել է H5N5 շտամը։ Նախկինում այս ենթատեսակը հայտնաբերվել է կենդանիների մոտ, բայց ոչ երբեք՝ մարդկանց»,- նշված է հաղորդագրությունում։
Առողջապահության դեպարտամենտը հայտնել է, որ այս ենթատեսակի տարածման ռիսկն այս պահին ցածր է։